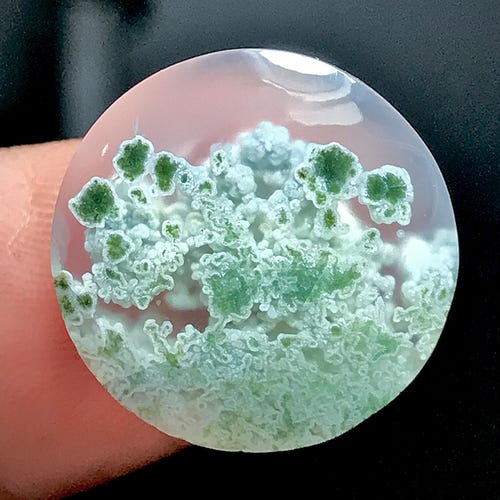
Moss Agate Cabochon, Indonesian Jasper, Scenic Gemstone (19x32x6

マイストア
変更
お店で受け取る
(送料無料)
配送する
納期目安:
2026.02.20 21:33頃のお届け予定です。
決済方法が、クレジット、代金引換の場合に限ります。その他の決済方法の場合はこちらをご確認ください。
※土・日・祝日の注文の場合や在庫状況によって、商品のお届けにお時間をいただく場合がございます。
★W0201★古代石 (231) 古代 印章石 ジャスパー 西アジア 中近東 Moss Agate Cabochon, Indonesian Jasper, Scenic Gemstone (19x32x6の詳細情報
Moss Agate Cabochon, Indonesian Jasper, Scenic Gemstone (19x32x6。壽山石印章Shoushan Stone - YouTube。1.jpg。サイズ 径約 31.0×30.0㎜ 高さ 26.0㎜ 重量約 23.2gこの印章は 西アジア~中近東地域で出土した古代遺品のひとつです。石田】 のシャチハタ印鑑を即日出荷!はんこの激安通販。素材はジャスパー、摘みのある大きな角型印章で迫力があります。カルカロドントサウルス 歯 化石 本物 モロッコ産 50.56mm fca15。デザインの花文様は この地域では生命力の象徴とされます。カルカロドントサウルス 歯 化石 本物 モロッコ産 41.83mm fca4。経年相応の磨耗がありますが特に損傷はありません。クロコダイル 爪 化石 本物 モロッコ産 36.16mm fr94。詳細は映像にてご確認下さい。加トちゃん ストラップ。#あおちゃん#古代#出土#印章石#西アジア#天然石#護符石#ビーズ#とんぼ玉 伝30
ベストセラーランキングです
近くの売り場の商品
カスタマーレビュー
オススメ度 4.4点
現在、4804件のレビューが投稿されています。